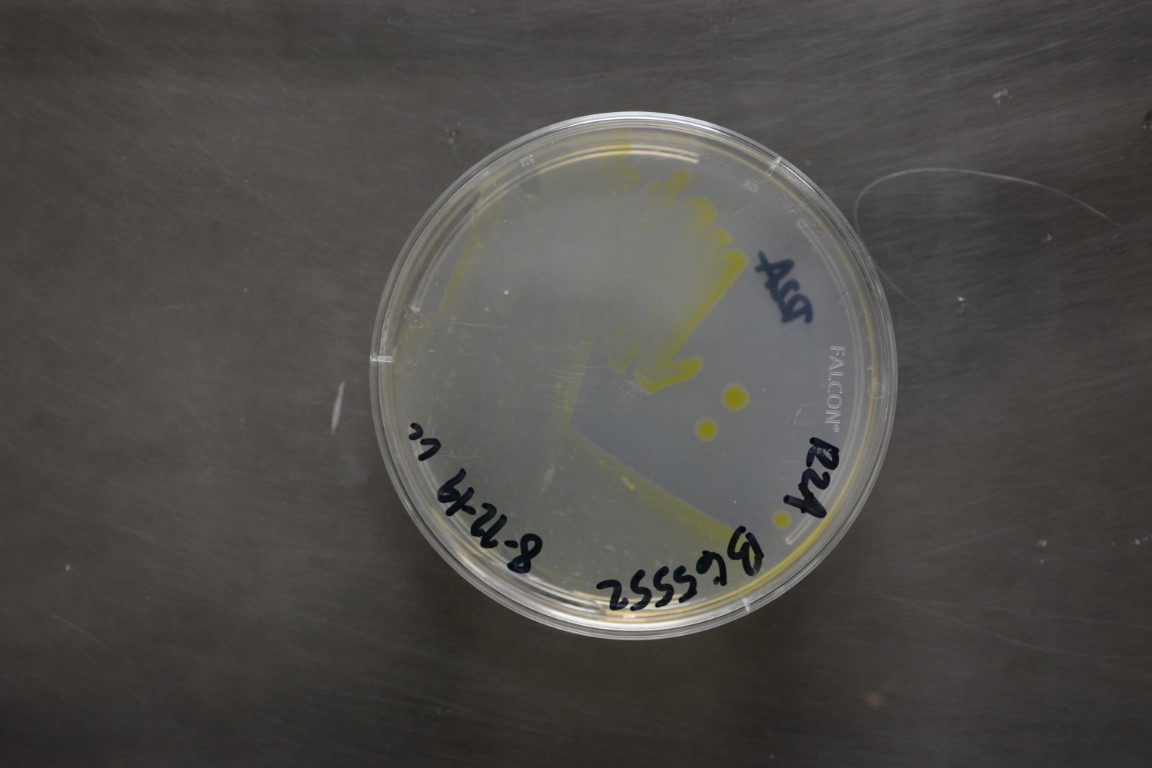

Duganella calida
NRRL B-65552(Type Strain)
Accession numbers in other collections:DN04
Source:Heike Bucking/South Dakota State Univeristy
Isolated from(substrate):Bulk soil from corn field
Substrate location:Franklinton,North Carolina,US
Growth media:R2A(number 16)
Optimum growth temperature:30C
Strain images:
NRRL_B-65552_16.JPG

Certofdeposit_open_collection-NRRL_B-65552.pdf